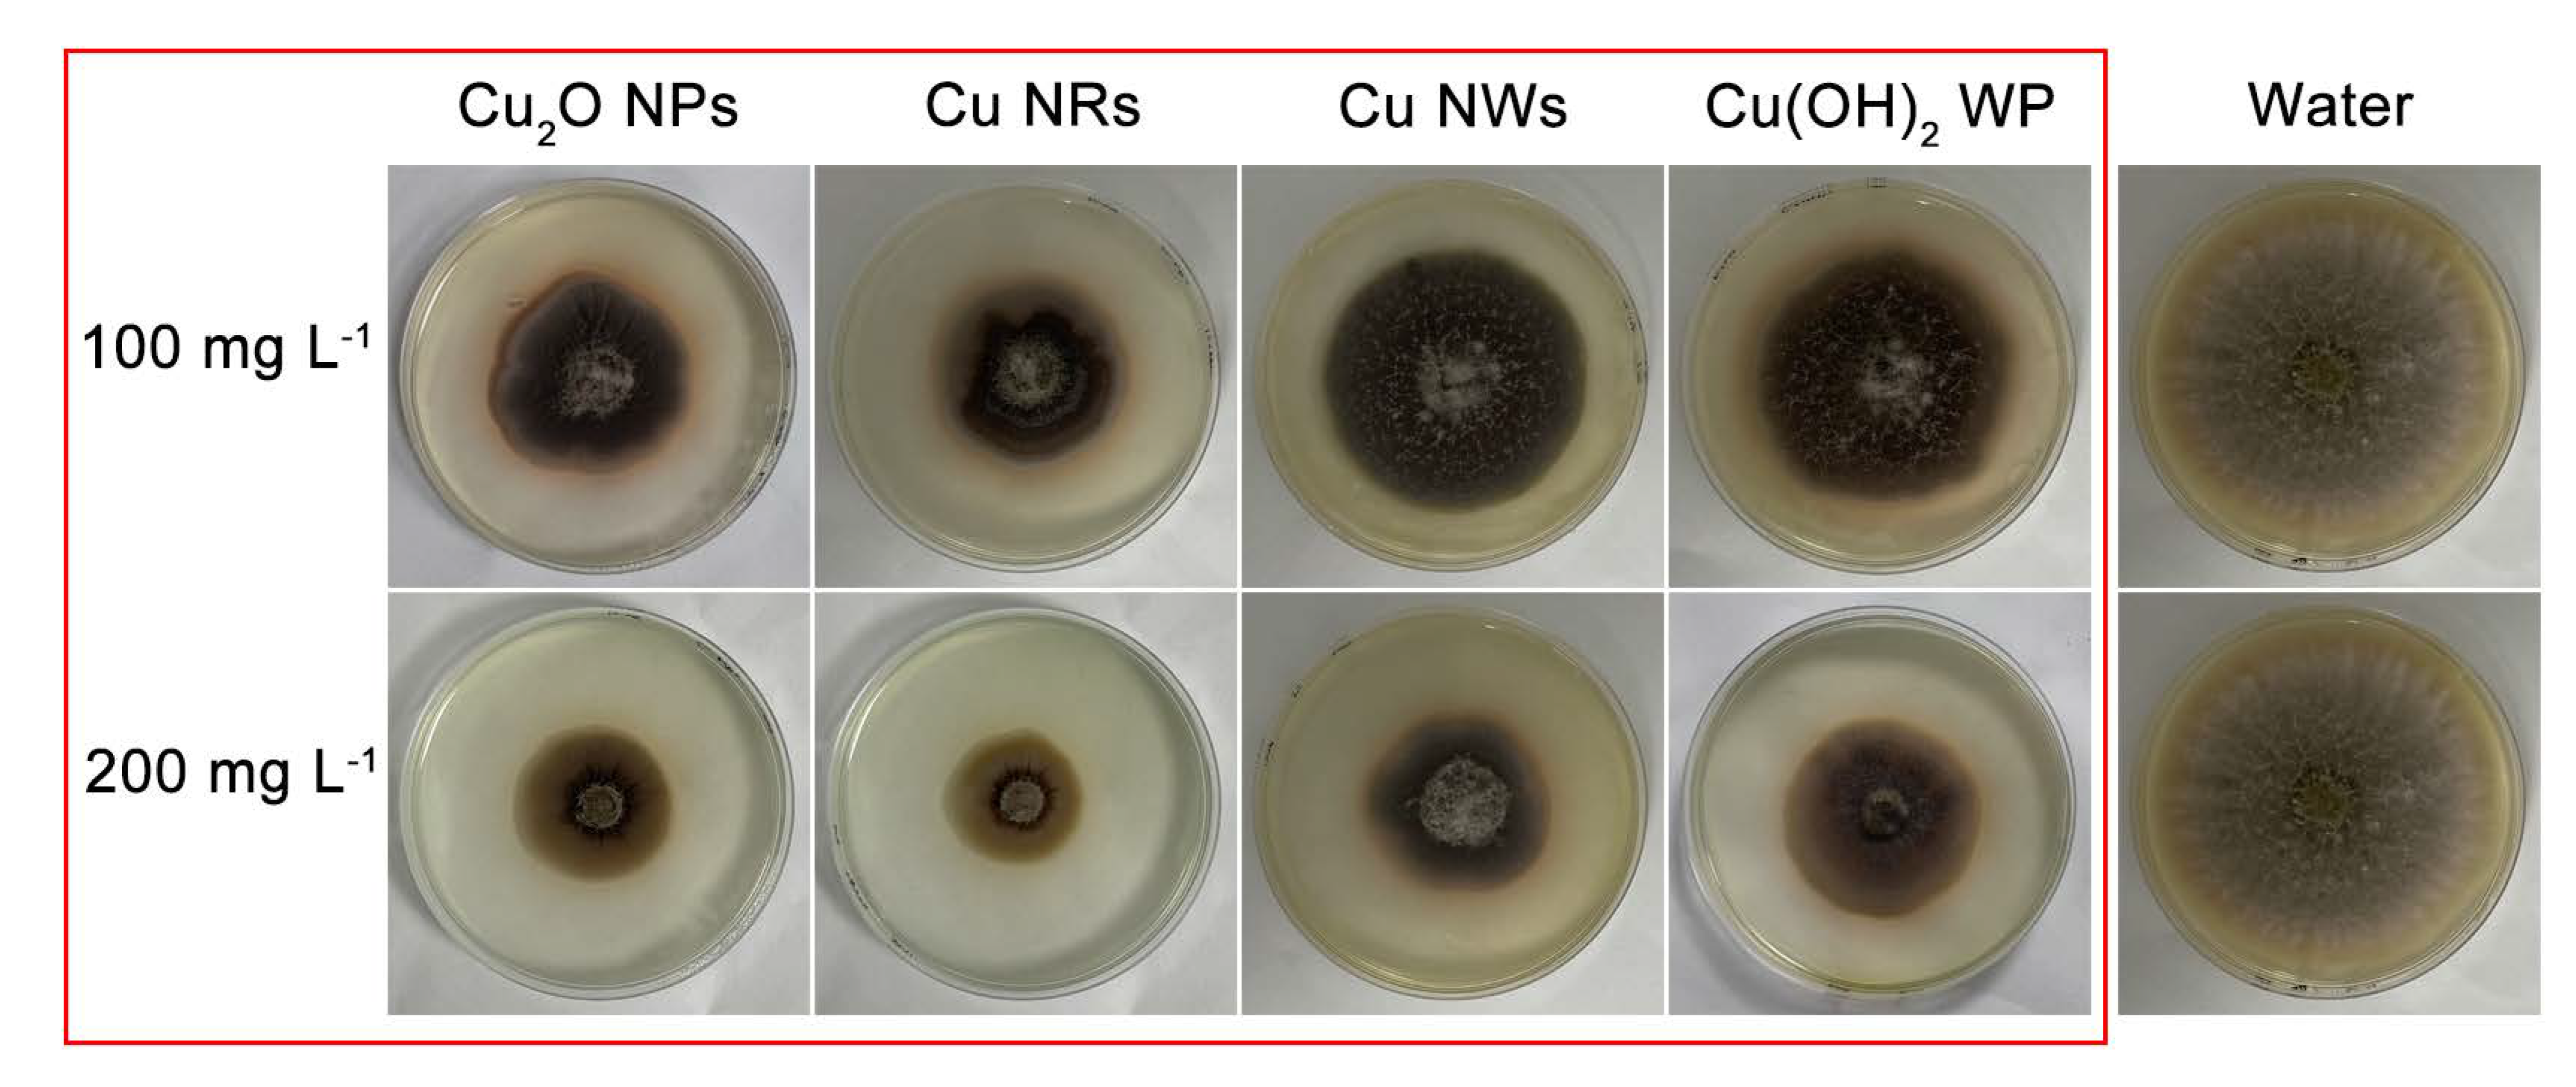
Ijms 24 09673 g004 Ijms 24 09673 g004

Differential Analysis of Three Copper-Based Nanomaterials with Different Morphologies to Suppress Alternaria alternata and Safety Evaluation
Abstract
1. Introduction
2. Results and Discussion
2.1. Cu-Based NMs Characterization
2.2. Antifungal and Soluble Protein Assay
2.3. pH Values for Cu-Based NMs
2.4. Safety Evaluation of Adult Zebrafish
3. Materials and Methods
3.1. Chemicals and Instruments
3.2. Preparation of Cu-Based NMs
3.3. Characterization of Cu-Based NMs
3.4. A. alternata Culture
3.5. Inhibitory Effects of Cu NMs on A. alternata In Vitro
3.6. Determination of Soluble Protein in Mycelia
3.7. pH Measurements
3.8. Safety Evaluation of Adult Zebrafish
3.9. Statistical Analysis
4. Conclusions
Supplementary Materials
Author Contributions
Funding
Institutional Review Board Statement
Informed Consent Statement
Data Availability Statement
Acknowledgments
Conflicts of Interest
References
- Kristl, J.; Sem, V.; Kristl, M.; Kramberger, B.; Lesnik, M. Effects of integrated and organic pest management with copper and copper-free preparations on tomato (Lycopersicum esculentum Mill.) fruit yield, disease incidence and quality. Food Chem. 2019, 278, 342–349. [Google Scholar] [CrossRef]
- Lafuente, M.T.; Sampedro, R.; Velez, D.; Romero, P. Deficient copper availability on organoleptic and nutritional quality of tomato fruit. Plant Sci. 2023, 326, 111537. [Google Scholar] [CrossRef] [PubMed]
- Dao, T.T.; Tran, T.T.; Nguyen, A.M.; Nguyen, L.N.; Pham, P.T.; Tsubota, T.; Nguyen, M.N. Fungicide application can intensify clay aggregation and exacerbate copper accumulation in citrus soils. Environ. Pollut. 2021, 288, 11703. [Google Scholar] [CrossRef]
- Pariona, N.; Mtz-Enriquez, A.I.; Sánchez-Rangel, D.; Carrión, G.; Paraguay-Delgado, F.; Rosas-Saito, G. Green-synthesized copper nanoparticles as a potential antifungal against plant pathogens. RSC Adv. 2019, 9, 18835–18843. [Google Scholar] [CrossRef]
- Lamichhane, J.R.; Osdaghi, E.; Behlau, F.; Koehl, J.; Jones, J.B.; Aubertot, J.-N. Thirteen decades of antimicrobial copper compounds applied in agriculture. A review. Agron. Sustain. Dev. 2018, 38, 28–45. [Google Scholar] [CrossRef]
- Gazzurelli, C.; Migliori, A.; Mazzeo, P.P.; Carcelli, M.; Pietarinen, S.; Leonardi, G.; Pandolfi, A.; Rogolino, D.; Pelagatti, P. Making Agriculture More Sustainable: An Environmentally Friendly Approach to the Synthesis of Lignin@Cu Pesticides. ACS Sustain. Chem. Eng. 2020, 8, 14886–14895. [Google Scholar] [CrossRef]
- Villanueva-Rey, P.; Vazquez-Rowe, I.; Quinteiro, P.; Rafael, S.; Goncalves, C.; Moreira, M.T.; Feijoo, G.; Arroja, L.; Dias, A.C. Regionalizing eco-toxicity characterization factors for copper soil emissions considering edaphic information for Northern Spain and Portuguese vineyards. Sci. Total Environ. 2019, 686, 986–994. [Google Scholar] [CrossRef]
- Stanislawska-Glubiak, E.; Korzeniowska, J. Fate of Copper in Soils from Different Fertilizer Doses in Relation to Environmental Risk Assessment. Pol. J. Environ. Stud. 2018, 27, 1735–1741. [Google Scholar] [CrossRef]
- Norgrove, L. Effects of different copper fungicide application rates upon earthworm activity and impacts on cocoa yield over four years. Eur. J. Soil Biol. 2007, 43, S303–S310. [Google Scholar] [CrossRef]
- Malhotra, N.; Ger, T.R.; Uapipatanakul, B.; Huang, J.C.; Chen, K.H.C.; Hsiao, C.D. Review of Copper and Copper Nanoparticle Toxicity in Fish. Nanomaterials 2020, 10, 1126. [Google Scholar] [CrossRef]
- Toth, G.; Hermann, T.; Da Silva, M.R.; Montanarella, L. Heavy metals in agricultural soils of the European Union with implications for food safety. Environ. Int. 2016, 88, 299–309. [Google Scholar] [CrossRef]
- Stern, B.R. Essentiality and Toxicity in Copper Health Risk Assessment: Overview, Update and Regulatory Considerations. J. Toxicol. Environ. Health-Part A-Curr. Issues 2010, 73, 114–127. [Google Scholar] [CrossRef] [PubMed]
- Tamm, L.; Thuerig, B.; Apostolov, S.; Blogg, H.; Borgo, E.; Corneo, P.E.; Fittje, S.; de Palma, M.; Donko, A.; Experton, C.; et al. Use of Copper-Based Fungicides in Organic Agriculture in Twelve European Countries. Agronomy 2022, 12, 673. [Google Scholar] [CrossRef]
- Arena, M.; Auteri, D.; Barmaz, S.; Bellisai, G.; Brancato, A.; Brocca, D.; Bura, L.; Byers, H.; Chiusolo, A.; Marques, D.C.; et al. Peer review of the pesticide risk assessment of the active substance copper compounds copper(I), copper(II) variants namely copper hydroxide, copper oxychloride, tribasic copper sulfate, copper(I) oxide, Bordeaux mixture. EFSA J. 2018, 16, 5152–5176. [Google Scholar] [CrossRef]
- Wang, D.; Saleh, N.B.; Byro, A.; Zepp, R.; Sahle-Demessie, E.; Luxton, T.P.; Ho, K.T.; Burgess, R.M.; Flury, M.; White, J.C.; et al. Nano-enabled pesticides for sustainable agriculture and global food security. Nat. Nanotechnol. 2022, 17, 347–360. [Google Scholar] [CrossRef] [PubMed]
- Rodriguez, H.S.; Hinestroza, J.P.; Ochoa-Puentes, C.; Sierra, C.A.; Soto, C.Y. Antibacterial Activity Against Escherichia coli of Cu-BTC (MOF-199) Metal-Organic Framework Immobilized onto Cellulosic Fibers. J. Appl. Polym. Sci. 2014, 131, 40815. [Google Scholar] [CrossRef]
- Mitra, D.; Li, M.; Kang, E.T.; Neoh, K.G. Transparent Copper-Based Antibacterial Coatings with Enhanced Efficacy against Pseudomonas aeruginosa. ACS Appl. Mater. Interfaces 2019, 11, 73–83. [Google Scholar] [CrossRef] [PubMed]
- Raf, A.; Ye, J.W.; Zhang, S.Q.; Qi, Y.; Wang, G.Y.; Che, Y.; Ning, G.T. Copper(ii)-based coordination polymer nanofibers as a highly effective antibacterial material with a synergistic mechanism. Dalton Trans. 2019, 48, 17810–17817. [Google Scholar] [CrossRef]
- Meghana, S.; Kabra, P.; Chakraborty, S.; Padmavathy, N. Understanding the pathway of antibacterial activity of copper oxide nanoparticles. RSC Adv. 2015, 5, 12293–12299. [Google Scholar] [CrossRef]
- Ren, J.; Wang, W.Z.; Sun, S.M.; Zhang, L.; Wang, L.; Chang, J. Crystallography Facet-Dependent Antibacterial Activity: The Case of Cu2O. Ind. Eng. Chem. Res. 2011, 50, 10366–10369. [Google Scholar] [CrossRef]
- Alzoubi, K.H.; Alshraiedeh, N.a.H.; Ammar, O.F.; Masadeh, M.M.; Al-Fandi, M.G.; Oweis, R.J.; Alsharedeh, R.H.; Alabed, R.A.; Hayajneh, R.H. Comparative Study of Antibacterial Activity of Different ZnO Nanoparticles, Nanoflowers, and Nanoflakes. Curr. Nanosci. 2022, 18, 758–765. [Google Scholar] [CrossRef]
- Ma, C.X.; Borgatta, J.; Hudson, B.G.; Tamijani, A.A.; De La Torre-Roche, R.; Zuverza-Mena, N.; Shen, Y.; Elmer, W.; Xing, B.S.; Mason, S.E.; et al. Advanced material modulation of nutritional and phytohormone status alleviates damage from soybean sudden death syndrome. Nat. Nanotechnol. 2020, 15, 1033–1042. [Google Scholar] [CrossRef] [PubMed]
- Sun, H.H.; Wang, L.; Zhang, B.Q.; Ma, J.H.; Hettenhausen, C.; Cao, G.Y.; Sun, G.L.; Wu, J.Q.; Wu, J.S. Scopoletin is a phytoalexin against Alternaria alternata in wild tobacco dependent on jasmonate signalling. J. Exp. Bot. 2014, 65, 4305–4315. [Google Scholar] [CrossRef] [PubMed]
- Kong, H.; Fu, X.C.; Chang, X.; Ding, Z.M.; Yu, Y.; Xu, H.S.; Wang, R.R.; Shan, Y.; Ding, S.H. The ester derivatives of ferulic acid exhibit strong inhibitory effect on the growth of Alternaria alternata in vitro and in vivo. Postharvest Biol. Technol. 2023, 196, 112158. [Google Scholar] [CrossRef]
- Zhang, J.R.; Cheng, X.W.; Chang, L.L.; Zhang, L.L.; Zhang, S.Y. Combined treatments of chitosan and sodium silicate to inhibit Alternaria alternata pathogens of postharvest winter jujube. Food Sci. Biotechnol. 2021, 30, 589–597. [Google Scholar] [CrossRef]
- Wang, F.; Saito, S.; Michailides, T.J.; Xiao, C.L. Baseline Sensitivity of Alternaria alternata and A. arborescens to Natamycin and Control of Alternaria Rot on Stored Mandarin Fruit. Plant Dis. 2021, 105, 3653–3656. [Google Scholar] [CrossRef]
- Meena, M.; Gupta, S.K.; Swapnil, P.; Zehra, A.; Dubey, M.K.; Upadhyay, R.S. Alternaria Toxins: Potential Virulence Factors and Genes Related to Pathogenesis. Front. Microbiol. 2017, 8, 1451. [Google Scholar] [CrossRef]
- Fetzner, R.; Seither, K.; Wenderoth, M.; Herr, A.; Fischer, R. Alternaria alternata transcription factor CmrA controls melanization and spore development. Microbiol.-Sgm 2014, 160, 1845–1854. [Google Scholar] [CrossRef]
- Rehnstrom, A.L.; Free, S.J. The isolation and characterization of melanin-deficient mutants of Monilinia fructicola. Physiol. Mol. Plant Pathol. 1996, 49, 321–330. [Google Scholar] [CrossRef]
- Babitskaia, V.G.; Shcherba, V.V.; Filimonova, T.V.; Grigorchuk, E.Z. Melanin pigments of the fungi Paecilomyces variotii and Aspergillus carbonarius. Prikl. Biokhimiia I Mikrobiol. 2000, 36, 153–159. [Google Scholar]
- Gaba, S.; Rai, A.K.; Varma, A.; Prasad, R.; Goel, A. Biocontrol potential of mycogenic copper oxide nanoparticles against Alternaria brassicae. Front. Chem. 2022, 10, 966396. [Google Scholar] [CrossRef]
- Grodetskaya, T.A.; Evlakov, P.M.; Fedorova, O.A.; Mikhin, V.I.; Zakharova, O.V.; Kolesnikov, E.A.; Evtushenko, N.A.; Gusev, A.A. Influence of Copper Oxide Nanoparticles on Gene Expression of Birch Clones In Vitro under Stress Caused by Phytopathogens. Nanomaterials 2022, 12, 864. [Google Scholar] [CrossRef] [PubMed]
- Keller, A.A.; Adeleye, A.S.; Conway, J.R.; Garner, K.L.; Zhao, L.J.; Cherr, G.N.; Hong, J.; Gardea-Torresdey, J.L.; Godwin, H.A.; Hanna, S.; et al. Comparative environmental fate and toxicity of copper nanomaterials. NanoImpact 2017, 7, 28–40. [Google Scholar] [CrossRef]
- Zhang, Y.J.; Ding, Z.C.; Zhao, G.; Zhang, T.; Xu, Q.H.; Cui, B.; Liu, J.X. Transcriptional responses and mechanisms of copper nanoparticle toxicology on zebrafish embryos. J. Hazard. Mater. 2018, 344, 1057–1068. [Google Scholar] [CrossRef] [PubMed]
- Singh, A.V.; Baylan, S.; Park, B.-W.; Richter, G.; Sitti, M. Hydrophobic pinning with copper nanowhiskers leads to bactericidal properties. PLoS ONE 2017, 12, e0175428. [Google Scholar] [CrossRef]
- Kora, A.J. Copper-based nanopesticides. In Copper Nanostructures: Next-Generation of Agrochemicals for Sustainable Agroecosystems; Elsevier: Amsterdam, The Netherlands, 2022; pp. 133–153. [Google Scholar]
- Luo, X.; Li, C.; Yang, D.; Liu, F.; Chen, Y. Sonochemical synthesis of porous Cu2O–Cu hollow spheres and their photo-catalysis. Mater. Chem. Phys. 2015, 151, 252–258. [Google Scholar] [CrossRef]
- Eisenman, H.C.; Casadevall, A. Synthesis and assembly of fungal melanin. Appl. Microbiol. Biotechnol. 2012, 93, 931–940. [Google Scholar] [CrossRef]
- Li, R.; Xu, W.Y.; Zong, Y.Y.; Wang, X.J.; Li, Y.C.; Bi, Y.; Prusky, D.B. Melanin synthesis gene Aapks contributes to appressorium formation, stress response, cell well integrity and virulence in Alternaria alternata. Postharvest Biol. Technol. 2023, 198, 112247. [Google Scholar] [CrossRef]
- Singh, K.; Yadav, V.B.; Yadav, U.; Nath, G.; Srivastava, A.; Zamboni, P.; Kerkar, P.; Saxena, P.S.; Singh, A.V. Evaluation of biogenic nanosilver-acticoat for wound healing: A tri-modal in silico, in vitro and in vivo study. Colloids Surf. A Physicochem. Eng. Asp. 2023, 670, 131575. [Google Scholar] [CrossRef]
- Albalghiti, E.; Stabryla, L.M.; Gilbertson, L.M.; Zimmerman, J.B. Towards resolution of antibacterial mechanisms in metal and metal oxide nanomaterials: A meta-analysis of the influence of study design on mechanistic conclusions. Environ. Sci.-Nano 2021, 8, 37–66. [Google Scholar] [CrossRef]
- Bezza, F.A.; Tichapondwa, S.M.; Chirwa, E.M.N. Fabrication of monodispersed copper oxide nanoparticles with potential application as antimicrobial agents. Sci. Rep. 2020, 10, 16680. [Google Scholar] [CrossRef] [PubMed]
- Giannousi, K.; Avramidis, I.; Dendrinou-Samara, C. Synthesis, characterization and evaluation of copper based nanoparticles as agrochemicals against Phytophthora infestans. RSC Adv. 2013, 3, 21743–21752. [Google Scholar] [CrossRef]
- Brzonkalik, K.; Hummer, D.; Syldatk, C.; Neumann, A. Influence of pH and carbon to nitrogen ratio on mycotoxin production by Alternaria alternata in submerged cultivation. AMB Express 2012, 2, 28. [Google Scholar] [CrossRef]
- Cao, F.J.; Liu, X.S.; Wang, C.J.; Zheng, M.Q.; Li, X.F.; Qiu, L.H. Acute and short-term developmental toxicity of cyhalofop-butyl to zebrafish (Danio rerio). Environ. Sci. Pollut. Res. 2016, 23, 10080–10089. [Google Scholar] [CrossRef]
- Zahangir, M.M.; Haque, F.; Mostakim, G.M.; Islam, M.S. Secondary stress responses of zebrafish to different pH: Evaluation in a seasonal manner. Aquac. Rep. 2015, 2, 91–96. [Google Scholar] [CrossRef]
- Bogdanovic, U.; Vodnik, V.; Mitric, M.; Dimitrijevic, S.; Skapin, S.D.; Zunic, V.; Budimir, M.; Stoiljkovic, M. Nanomaterial with High Antimicrobial Efficacy-Copper/Polyaniline Nanocomposite. ACS Appl. Mater. Interfaces 2015, 7, 1955–1966. [Google Scholar] [CrossRef]
- Pereira, T.C.; Campos, M.M.; Bogo, M.R. Copper toxicology, oxidative stress and inflammation using zebrafish as experimental model. J. Appl. Toxicol. 2016, 36, 876–885. [Google Scholar] [CrossRef] [PubMed]
- Ma, B.J.; Wang, S.; Liu, F.; Zhang, S.; Duan, J.Z.; Li, Z.; Kong, Y.; Sang, Y.H.; Liu, H.; Bu, W.B.; et al. Self-Assembled Copper Amino Acid Nanoparticles for in Situ Glutathione and H2O2 Sequentially Triggered Chemodynamic Therapy. J. Am. Chem. Soc. 2019, 141, 849–857. [Google Scholar] [CrossRef]
- Liu, X.J.; Yang, W.X.; Chen, L.L.; Jia, J.B. Synthesis of copper nanorods for non-enzymatic amperometric sensing of glucose. Microchim. Acta 2016, 183, 2369–2375. [Google Scholar] [CrossRef]
- Mohl, M.; Pusztai, P.; Kukovecz, A.; Konya, Z.; Kukkola, J.; Kordas, K.; Vajtai, R.; Ajayan, P.M. Low-temperature large-scale synthesis and electrical testing of ultralong copper nanowires. Langmuir 2010, 26, 16496–16502. [Google Scholar] [CrossRef]
- Ballestero-Tellez, M.; Docobo-Perez, F.; Rodriguez-Martinez, J.M.; Conejo, M.C.; Ramos-Guelfo, M.S.; Blazquez, J.; Rodriguez-Bano, J.; Pascual, A. Role of inoculum and mutant frequency on fosfomycin MIC discrepancies by agar dilution and broth microdilution methods in Enterobacteriaceae. Clin. Microbiol. Infect. 2017, 23, 325–331. [Google Scholar] [CrossRef] [PubMed]
- Bradford, M.M. A rapid and sensitive method for the quantitation of microgram quantities of protein utilizing the principle of protein-dye binding. Anal. Biochem. 1976, 72, 248–254. [Google Scholar] [CrossRef] [PubMed]
- OECD. OECD guidelines for the testing of chemicals. In Section 2: Effects on Biotic Systems Test No. 203: Fish, Acute Toxicity (FET) Test; OECD 203; Organization for Economic Cooperation and Development: Paris, France, 1992. [Google Scholar]
- Zhdanov, V.P. Kinetic model of oxidation of metal nanoparticles: Cabrera-Mott and Kirkendall effects. Surf. Sci. 2019, 684, 24–27. [Google Scholar] [CrossRef]
- Parada, J.; Rubilar, O.; Diez, M.C.; Cea, M.; Sant’Ana da Silva, A.; Rodriguez-Rodriguez, C.E.; Tortella, G.R. Combined pollution of copper nanoparticles and atrazine in soil: Effects on dissipation of the pesticide and on microbiological community profiles. J. Hazard. Mater. 2019, 361, 228–236. [Google Scholar] [CrossRef] [PubMed]

| Target | Regression Equation | LC50 (mg L−1) | 95% Confidence Limit (mg L−1) | R2 |
|---|---|---|---|---|
| Cu2O NPs | y = 1.26 + 4.26x | 0.52 | 0.40–0.65 | 0.949 |
| Cu NRs | y = −0.75 + 6.84x | 1.31 | 1.15–1.48 | 0.951 |
| Cu NWs | y = −2.71 + 3.88x | 5.27 | 3.56–7.33 | 0.903 |
Disclaimer/Publisher’s Note: The statements, opinions and data contained in all publications are solely those of the individual author(s) and contributor(s) and not of MDPI and/or the editor(s). MDPI and/or the editor(s) disclaim responsibility for any injury to people or property resulting from any ideas, methods, instructions or products referred to in the content. |
© 2023 by the authors. Licensee MDPI, Basel, Switzerland. This article is an open access article distributed under the terms and conditions of the Creative Commons Attribution (CC BY) license (https://creativecommons.org/licenses/by/4.0/).
Share and Cite
Yuan, Z.; Li, Y.; He, Y.; Qian, K.; Zhang, Y. Differential Analysis of Three Copper-Based Nanomaterials with Different Morphologies to Suppress Alternaria alternata and Safety Evaluation. Int. J. Mol. Sci. 2023, 24, 9673. https://doi.org/10.3390/ijms24119673
Yuan Z, Li Y, He Y, Qian K, Zhang Y. Differential Analysis of Three Copper-Based Nanomaterials with Different Morphologies to Suppress Alternaria alternata and Safety Evaluation. International Journal of Molecular Sciences. 2023; 24(11):9673. https://doi.org/10.3390/ijms24119673
Chicago/Turabian StyleYuan, Zitong, Yiwei Li, Yuke He, Kun Qian, and Yongqiang Zhang. 2023. "Differential Analysis of Three Copper-Based Nanomaterials with Different Morphologies to Suppress Alternaria alternata and Safety Evaluation" International Journal of Molecular Sciences 24, no. 11: 9673. https://doi.org/10.3390/ijms24119673
APA StyleYuan, Z., Li, Y., He, Y., Qian, K., & Zhang, Y. (2023). Differential Analysis of Three Copper-Based Nanomaterials with Different Morphologies to Suppress Alternaria alternata and Safety Evaluation. International Journal of Molecular Sciences, 24(11), 9673. https://doi.org/10.3390/ijms24119673

